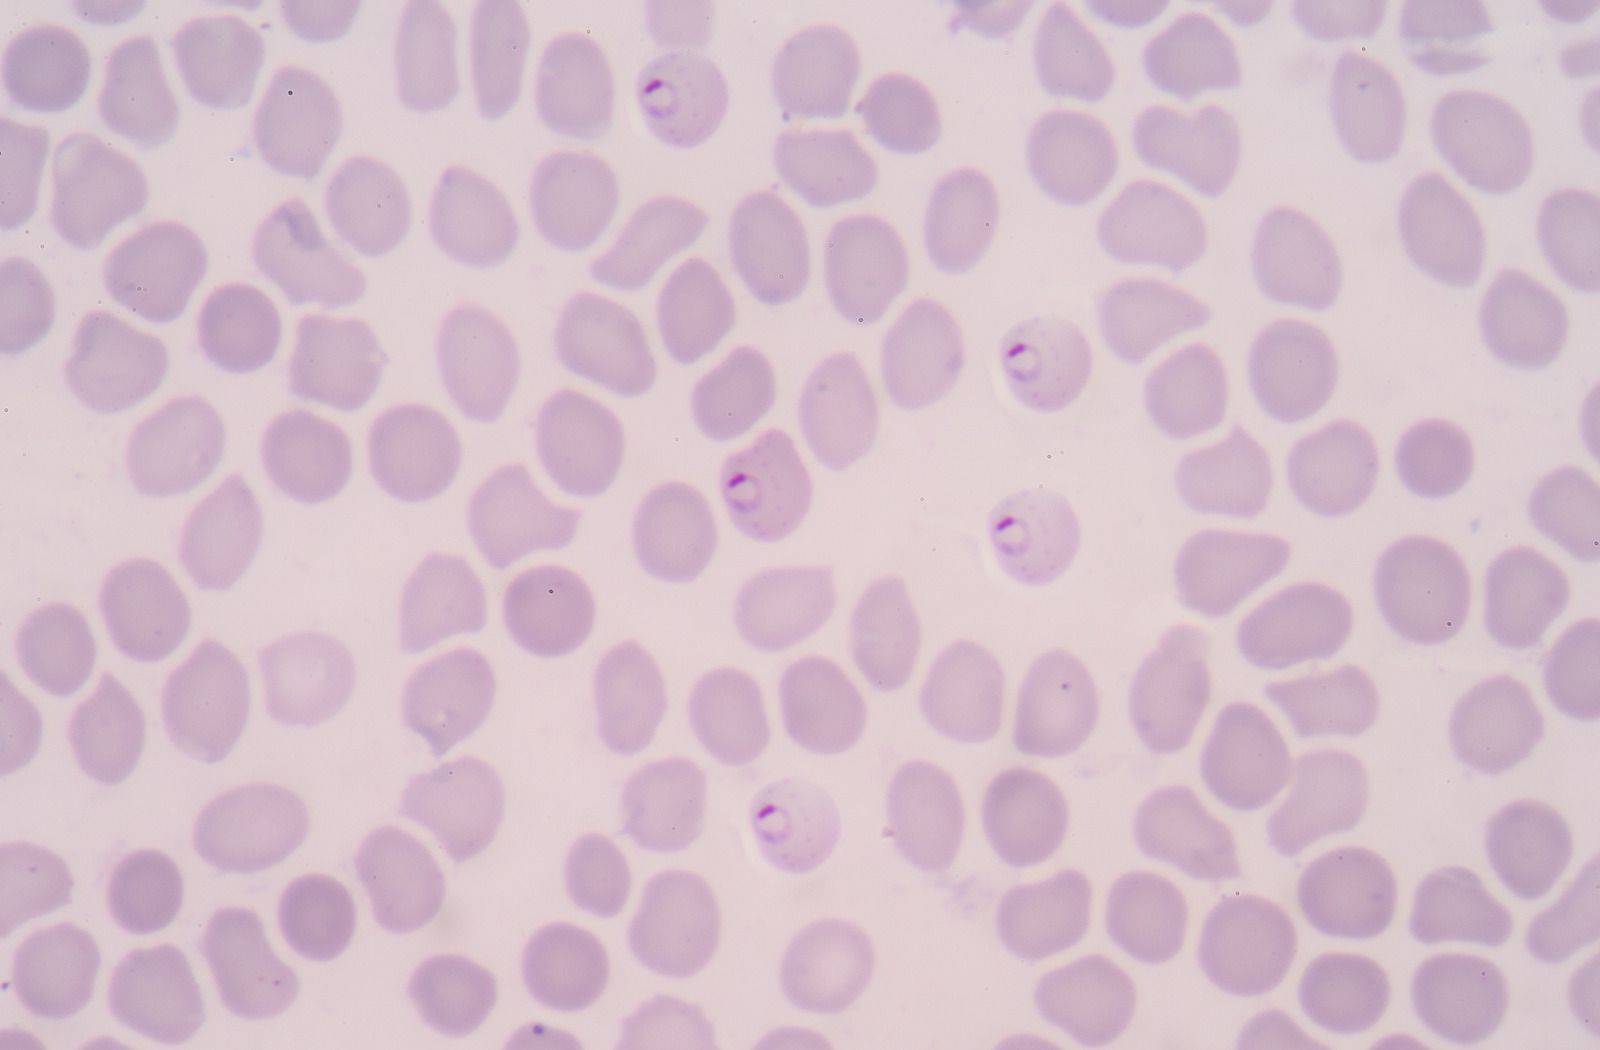

MICROBIOLOGIE

Un traitement adapté des infections bactériennes repose sur la mise en évidence de la bactérie en cause.
Grace aux techniques conventionnelles en bactériologie comme la coloration gramm, la culture sur milieux sélectifs et enrichis, on arrive à la mise en évidence de la souche bactérienne et par la suite on procède à l’identification puis à la réalisation de l´antibiogramme selon les directives "EUCAST".

Le diagnostic des maladies virales repose sur la mise en évidence directe ou indirecte du virus en cause par des techniques sérologiques et de biologie moléculaire.
A titre d'exemple, le virus Varicelle Zona peut causer non seulement des zonas cutanés mais aussi des méningites, hépatites et peut toucher beaucoup d'autres organes.
Le diagnostic biologique des parasitoses repose sur la mise en évidence directe ou indirecte du parasite en cause.
Que ça soit recherche de parasites dans les selles, scotch-test, sang (goutte épaisse), urine ou autre liquide biologique, notre laboratoire a établi les méthodes diagnostiques nécessaires pour chaque indication.

Les mycoses ou infections fongiques sont dûes à des microchampignons qui atteignent les téguments (peau, muqueuses, ongles, cheveux).
En cas d'immunodépression profonde, ces agents peuvent causer des mycoses systémiques.
L'analyse de l'aspect des conidies à la coloration au bleu de lactophénol ainsi que l'aspect macroscopique et la vitesse de croissance des dermatophytes, tous sont des critères d'identification. Ces examens durent plusieurs semaines.